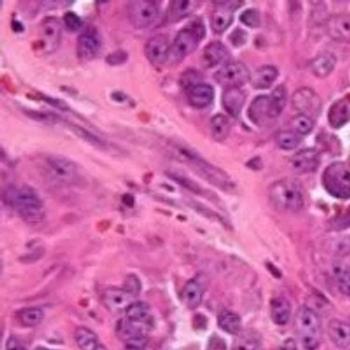

The phase 3 KEYNOTE-598 trial evaluating the dual immunotherapy combination comprised of pembrolizumab and ipilimumab as frontline treatment in patients with metastatic non–small cell lung cancer who have a PD-L1 tumor proportion score of 50% or greater and do not harbor any EGFR or ALK aberrations has been discontinued.